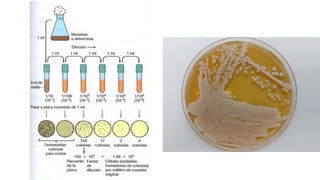

Incrustar presentación
Descargar para leer sin conexión















El documento presenta una práctica sobre el aislamiento y purificación de levaduras a partir de fermentados de frutas. Los estudiantes se dividirán en 3 grupos para desarrollar de manera independiente un proceso de aislamiento y purificación de levaduras, el cual deberán esquematizar en un diagrama de flujo completo utilizando bibliografía provista. Cada grupo tendrá 2 horas para entregar un informe en formato PowerPoint con un máximo de 20 diapositivas.